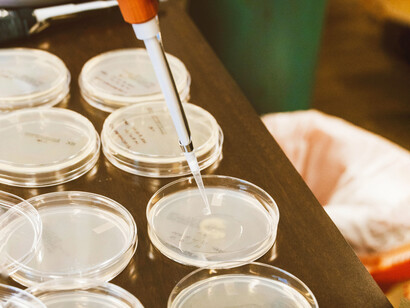
Las investigaciones en nanotecnología han dado lugar a materiales con propiedades autorregenerativas y mayor biocompatibilidad
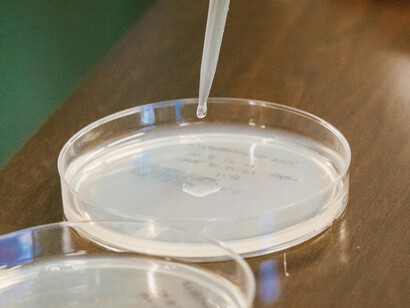
El desarrollo de hidrogeles sensibles al pH ha permitido avances significativos en la liberación controlada de fármacos
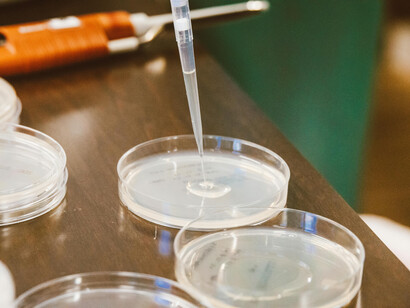
La nanotecnología ha permitido diseñar biomateriales que imitan estructuras biológicas a escala microscópica, mejorando la regeneración de tejidos

Los biomateriales inteligentes están transformando la medicina moderna, especialmente en campos como la medicina regenerativa y la ingeniería de prótesis avanzadas. Estos materiales, que responden a estímulos específicos del entorno biológico, permiten la reparación de tejidos, la integración de prótesis y el desarrollo de dispositivos médicos más eficientes. En este artículo, exploraremos el concepto de biomateriales inteligentes, sus aplicaciones más innovadoras, sus avances tecnológicos, y los retos que aún deben superarse para su implementación masiva en la práctica médica.
¿Qué son los biomateriales inteligentes?
Los biomateriales inteligentes son materiales diseñados para interactuar con su entorno biológico de manera dinámica. A diferencia de los biomateriales convencionales, que permanecen estables, los biomateriales inteligentes responden activamente a estímulos como cambios en temperatura, pH, campos eléctricos, luz o campos magnéticos. Esta capacidad de adaptación los hace ideales para aplicaciones médicas en las que se necesita respuesta en tiempo real ante condiciones fisiológicas cambiantes.
Clasificación según los estímulos
Sensibles a la temperatura: Cambian su forma o propiedades cuando se ven afectados por variaciones térmicas.
Sensibles al pH: Se modifican en entornos ácidos o básicos, lo cual es útil para la liberación controlada de medicamentos.
Electroactivos: Responden a impulsos eléctricos y pueden cambiar su forma o estructura, lo que permite el desarrollo de prótesis avanzadas que interactúan con el sistema nervioso.
Fotoreactivos: Modifican sus propiedades cuando se exponen a la luz, lo que permite aplicaciones en cirugía mínimamente invasiva y tratamientos de regeneración celular.
Magnetoactivos: Responden a campos magnéticos, lo que facilita el desarrollo de sistemas para la liberación controlada de fármacos y aplicaciones de imágenes biomédicas.
Avances recientes en biomateriales inteligentes
Nanotecnología y nanomateriales
La nanotecnología ha permitido la creación de biomateriales con propiedades únicas que no solo mejoran la integración de dispositivos médicos en el cuerpo, sino que también permiten la autorregeneración de tejidos y la mejora de la biocompatibilidad. Los nanomateriales, como las nanopartículas de carbono, se están utilizando para modificar las propiedades mecánicas y químicas de los biomateriales inteligentes, lo que aumenta su rendimiento.
Incorporación de dispositivos electrónicos
El avance de los dispositivos electrónicos portátiles ha abierto nuevas posibilidades en el campo de los biomateriales inteligentes. Sensores implantables, dispositivos de monitoreo continuo y sistemas de retroalimentación han sido integrados a estos materiales, lo que permite la personalización del tratamiento médico y la monitorización constante de la salud de los pacientes.
Aplicaciones en medicina regenerativa
La medicina regenerativa es un campo innovador que busca restaurar la función de órganos y tejidos dañados mediante el uso de biomateriales inteligentes. Estos biomateriales no solo ayudan a reparar o reemplazar tejidos dañados, sino que también juegan un papel crucial en la regeneración natural del cuerpo.
Ingeniería de tejidos
Los biomateriales inteligentes desempeñan un papel crucial en la ingeniería de tejidos, ya que facilitan la regeneración celular y la creación de estructuras tisulares complejas. Los andamios biodegradables, diseñados para imitar la matriz extracelular, permiten el crecimiento celular y la formación de nuevos tejidos. Estos andamios se pueden cargar con factores de crecimiento o células madre que se liberan en respuesta a estímulos específicos, como cambios de pH o temperatura, lo que acelera la regeneración.
Regeneración ósea
La regeneración ósea es uno de los campos más destacados en la medicina regenerativa. Los biomateriales osteoinductores, cargados con factores específicos que estimulan la formación ósea, han mostrado resultados prometedores en el tratamiento de fracturas complejas. Además, los biomateriales con propiedades electroactivas están siendo utilizados para simular las condiciones mecánicas del hueso, favoreciendo la regeneración ósea acelerada.
Sistemas de liberación de fármacos controlada
La liberación controlada de fármacos es otra aplicación fundamental de los biomateriales inteligentes. Estos materiales permiten la administración precisa de medicamentos en función de las condiciones locales del tejido, como el pH o la temperatura. Por ejemplo, los hidrogeles inteligentes pueden liberar fármacos de manera controlada para tratar enfermedades crónicas o infecciones locales. Este sistema mejora la eficacia del tratamiento y minimiza los efectos secundarios.
Innovaciones en prótesis avanzadas
El desarrollo de prótesis avanzadas ha sido uno de los avances más significativos en el campo de los biomateriales inteligentes. Las prótesis convencionales, aunque funcionales, a menudo carecen de la capacidad de integrarse de manera efectiva con el cuerpo humano. Sin embargo, con los biomateriales inteligentes, las prótesis ahora pueden ofrecer movimientos más naturales, mayor confort y una integración más eficaz con los sistemas nervioso y musculoesquelético.
Prótesis mioeléctricas
Las prótesis mioeléctricas, que son capaces de responder a las señales eléctricas del sistema nervioso o los músculos, permiten movimientos controlados de forma más precisa. Estos dispositivos utilizan sensores que capturan las señales electromiográficas generadas por los músculos, lo que permite a la persona controlar su prótesis de manera más intuitiva.
Prótesis autónomas y biohíbridas
Las prótesis autónomas son sistemas que pueden ajustar su movimiento en tiempo real según las necesidades del usuario. Integrando sensores sensibles a la presión y a los cambios en el entorno, estas prótesis se adaptan a las condiciones dinámicas, mejorando la movilidad y reduciendo el desgaste de los componentes. Las prótesis biohíbridas, por otro lado, combinan elementos biológicos y artificiales. Un ejemplo es el uso de polímeros electroactivos que simulan la contracción muscular, ofreciendo una funcionalidad similar a los músculos humanos.
Avances en bioimpresión y fabricación de prótesis personalizadas
La bioimpresión 3D ha abierto un abanico de posibilidades para la fabricación de prótesis personalizadas, adaptadas anatómicamente a cada paciente. Además de permitir la creación de prótesis de mejor ajuste, la bioimpresión también está siendo utilizada para crear estructuras biológicas complejas que pueden ser implantadas en el cuerpo para regenerar tejidos. Se están desarrollando "bio-tintas" que responden a estímulos eléctricos, lo que promete una mejor integración con los tejidos vivos.
Desafíos en el desarrollo de biomateriales inteligentes
A pesar de los avances en biomateriales inteligentes, aún existen varios desafíos que deben ser superados antes de que estas tecnologías puedan implementarse de manera masiva en la práctica clínica.
Biocompatibilidad prolongada
Uno de los mayores desafíos es garantizar que los biomateriales no solo sean biocompatibles a corto plazo, sino que también mantengan esta biocompatibilidad a largo plazo, evitando reacciones inmunológicas o rechazo.
Durabilidad y resistencia mecánica
Los biomateriales inteligentes deben ser capaces de soportar las fuerzas mecánicas y tensiones que ocurren dentro del cuerpo humano sin perder sus propiedades. La resistencia a la degradación a lo largo del tiempo es crucial para garantizar que los implantes y prótesis sigan siendo efectivos.
Integración con el sistema nervioso
El desarrollo de prótesis que se integren de manera efectiva con el sistema nervioso central sigue siendo uno de los mayores retos. La capacidad de controlar una prótesis de manera intuitiva, como si fuera una parte del cuerpo, requiere avances en neurociencia y tecnologías de comunicación cerebro-computadora.
Aspectos éticos y sociales
El avance de las tecnologías de biomateriales inteligentes también plantea importantes cuestiones éticas. Por ejemplo, la modificación del cuerpo humano mediante prótesis avanzadas o biomateriales inteligentes podría generar debates sobre la identidad corporal y el acceso a estas tecnologías. Además, la integración de dispositivos electrónicos en el cuerpo humano genera preocupaciones sobre la privacidad y la seguridad de los datos.
Conclusiones
Los biomateriales inteligentes están marcando una nueva era en la medicina regenerativa y la ingeniería de prótesis. Gracias a sus capacidades de adaptación y respuesta a estímulos, ofrecen soluciones revolucionarias para la reparación de tejidos y la mejora de las prótesis. Aunque persisten desafíos tecnológicos y éticos, el futuro de estos materiales es prometedor, y continúan siendo un área de investigación activa en el campo de la medicina.